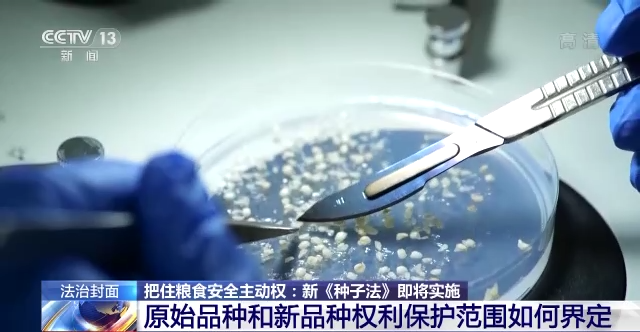

春节假期,匆匆而过,相信不少人还在回味这些天吃到的美食。同样的蔬果,可能却是不同的品种,也有着不同的口感。2022年3月1日即将实施的新《种子法》,聚焦植物新品种知识产权保护,提高法治化水平,在育种者、生产经营者、使用者之间建立平衡的权利义务关系,为原始创新提供法治保障。
北京市民 谷先生:咱们以前吃的西红柿是你只要是咬一口,有那种西红柿的香味,说我这个是西红柿味。现在你咬一口西红柿可能就没那种味道,就是有西红柿的形状颜色,但是你说那味道差得就太远了。
老谷是土生土长的北京昌平人,这个春节,老谷家年夜饭共准备了22道菜。他所感觉到的西红柿的变化,其实隐藏着与种子有关的秘密。

以西红柿为例,西红柿原产南美洲的秘鲁、厄瓜多尔等地,后传至墨西哥,驯化为栽培种,约在明代万历年间传至中国。记忆中小时候吃的西红柿,大多皮薄汁多味浓,但易腐烂,不耐运输。随着西红柿种植的商业化,为了方便远途运输、长期储存,减少运输销售损耗,适应丰富的市场需求,又引进和培育了各种不同的西红柿品种,有鲜食品种、罐装品种和加工品种,有不同颜色的品种,有不同果形的品种,有不同生长期的品种,还有不同酸甜度的品种,满足人们日益多元化的消费需求。
还有很多我们熟悉的食材,种源并不在中国。

这是我们经常食用的白色金针菇,它的菌种几乎都来自日本一家公司。虽然我国早在上个世纪80年代末就在栽培金针菇,但是我们的金针菇品种都是黄色,所以,对这种白色的金针菇,我国每年要花费三四千万元进口它的菌种。
谢永盾是中国农业科学院作物科学研究所的副研究员,从事小麦育种十几年。

中国农业科学院作物科学研究所副研究员 谢永盾:我们的梦想其实很简单,一个是让我们的国民能够吃饱,这是我们最基础的目标,在吃饱的基础上要让大家吃好,要能够吃出来我们想要的味道。
舌尖上的鲜美食材,除了部分来自野生生物资源,更多的是来自人工养殖。对人工养殖来说,不管是动物,还是植物,种源都至关重要。
种业科技自强自立、种源自主可控,是保障国家粮食安全的重要基础,而建立激励和保护原始创新的种业法律制度,是“打好种业翻身仗”的关键。

2021年12月24日,全国人大常委会通过了修改《种子法》的决定,自2022年3月1日起施行,这是《种子法》的第四次修订,全面强化了品种权的保护力度,将我国植物新品种保护水平推向新高度。

1978年改革开放后我国种业发展史历经了三次大的变革。从1979年开始到2000年《种子法》出台前,是“四化一供”阶段,就是以县为单位组织统一供种,实行种子生产专业化、加工机械化、质量标准化和品种布局区域化,这是第一次大变革。

中国社会科学院法学研究所副研究员 李菊丹:农民对种子需求的量和多样性,从90年代中末期之后就开始变得多样化了。这种(种子)单一的供给的形式,(以及)科研的这种体制,还有(资源)配给的这种方式,也难以适应当时的一个市场需求。那么国家肯定也是都能够发现到各个领域的这样的一种变化,然后开始出台(种子法)。种子法是管理种子市场的需要来出台的。

2000年12月1日,《种子法》正式出台实施。从此,我国正式迈进种子市场化阶段,打破行政区划垄断经营种子,鼓励科研单位建立种子公司,将竞争性机制引进种子行业,这是第二次大变革。
中国社会科学院法学研究所副研究员 李菊丹:(当时的《种子法》)内容主要倾向于应该是确立一些种子企业的地位,就是市场化的这种地位。种子的生产销售要开始市场化运营,而需要有一个法律对它进行规制管理。

2011年,《国务院关于加快推进现代农作物种业发展的意见》出台,我国进入现代种子产业阶段,建立起以产业为导向、基地为依托、产学研相结合、育繁推一体化的产业体系,这是第三次大变革。

中国社会科学院法学研究所副研究员 李菊丹:以企业为主体的申请品种权的数量明显增加,企业育种创新的地位逐渐开始起来。因为要发展现代种业,这个种业一定是以市场为机制建立起来的,整个的一个种业的(产业)链条。

植物新品种是一种有生命的发明,伴随我国种业的不断发展,2015年,《种子法》在2004年、2013年两次修改后,迎来第三次修改,这次修改首次设立了植物新品种保护专章。

中国社会科学院法学研究所副研究员 李菊丹:条例(1997年制定的《植物新品种保护条例》)相对来说位阶比较低,另外对某些民事的赔偿没有在法律当中得到体现。到了2015年的时候,就把种子法当中单独设立了一个植物新品种保护,第二个是改革了(主要农作物)品种审定制度,增加了品种登记制度,表明了品种权要跟(品种创新)保护,要和种子市场的管理紧密结合在一起。
保护创新 新法从哪些方面进行重要修改
保护知识产权就是保护创新,即将于3月1日实施的第四次修改的《种子法》,从哪些权利需要保护、如何保护等方面进行了重要修改。
这是国际科技期刊《自然—植物》近期刊登的一项科研成果,是我国科学家在小麦基因育种方面的又一大突破。
中国农业科学院作物科学研究所叶兴国团队,用13年科技攻关,在30多个候选小麦再生基因样本中,发现了小麦沃克斯五基因,利用这个基因辅助基因工程育种,有望改进优良小麦品种在抗病性、抗逆性和品质方面存在的缺点,延长优良品种的寿命。

中国农业科学院作物科学研究所研究员 叶兴国:比如说我们国家有个非常著名的春小麦品种叫“宁春4号”,它的产量非常高,品质也非常好,但是它有个非常大的缺点就是不抗小麦白粉病。我们通过转基因的方法或者是基因编辑的方法,将一个抗白粉病基因转到“宁春4号”里面。通过基因编辑的方法,它就获得了对白粉病的抗性。获得这个抗病性之后,它就可以在生产上继续利用十年、二十年。
专家表示,利用这个再生基因可以对几乎所有小麦品种进行转基因改良和基因编辑改良。

基因编辑技术的创新,为植物新品种保护带来了一个难题,就是通过基因编辑等新技术手段,对原有品种进行改良,形成新的植物品种,能否获得独立的植物新品种权保护呢?例如,叶兴国教授提到的小麦品种“宁春4号”,如果导入这个抗白粉病基因,形成新的植物品种,与“宁春4号”之间在法律上具有什么关系?
实践中,通过系统选育、转基因获得、连续回交或者诱变等等不同的育种方式,都有可能在别人培育而成的优质品种上产生新的植物品种。那么,原始品种和新品种的权利保护范围该如何界定呢?

中国农业科学院作物科学研究所副研究员 谢永盾:我们审定一个小麦品种大概需要8到10年的时间。也就是说从一开始我们两个亲本进行杂交开始,我们形成稳定的品系,包括中间我们利用一些其他(技术)手段作为快速繁殖,之后还有一个我们国家的区试过程,最终下来我们要形成一个品种,大概是8到10年的时间。我们最担心的还是这个品种很容易就被别人借鉴和抄袭。
一方面,有人提出,很多农作物育种周期长、投入大、风险高,原始品种育种人用十几年或一生的心血,甚至通过几代人的努力才能培育出一个突破性的新品种。而后来人在原始品种上稍加改造,就能得到一个新品种,在某些情况下,新品种性状的改变并无实际生产意义,如果在此种情况下,赋予新品种独立的植物品种权保护,这对原始品种育种人来说,明显不公平。

中国社会科学院法学研究所副研究员 李菊丹:如果(你培育)一个原始创新的成果出来,可以随便让人使用的话,这个原始创新的动力就明显不足。这个不足虽然是短期内看不出来,但长期内就会出现模仿育种,修饰性育种很多。最后造成了这一个作物的育种基础越来越狭窄,就像有点近亲繁殖的。一旦遇到了某些突发的自然灾害或什么(病虫害),那么我们的品种种子的安全、粮食的安全就会受到影响。
另一方面,有人提出,如果不给予新品种植物新品种权,就有可能会造成原始品种育种者的故步自封,从而遏制对原有品种的改良创新活动。

就此,这次新修订的《种子法》借鉴国际植物新品种保护公约1991文本,引入了“实质性派生品种”制度。新《种子法》第九十条明确规定,实质性派生品种是指由原始品种实质性派生,或者由该原始品种的实质性派生品种派生出来的品种,与原始品种有明显区别,并且除派生引起的性状差异外,在表达由原始品种基因型或者基因型组合产生的基本性状方面与原始品种相同。

中国社会科学院法学研究所副研究员 李菊丹:所以建立这个制度,只要是跟这个品种作为一个基础的形成后续的第一代派生品实质性派生品种,第二代派生品种的这些商业性的利用,它应当获得原始品种权利人的许可。这个许可的意思其实就是你要向他交费付费,使得他这样的一个育种创新能够得到延续。
实质性派生品种制度的引入,既表达了国家保护原始育种创新,遏制“剽窃育种”的决心,也为植物新品种的后续改良和推广应用,建立了合理的利益分享机制。

中国社会科学院法学研究所副研究员 李菊丹:有了这个(实质性派生品种)制度的支持,他们(原始品种权人)就可以放心了,所有人包括用换马甲方式的使用方式,或者什么样的生物技术,这样的育种方式进行改造的行为,都将是对它这个品种的使用,他(原始品种权人)都能从这个当中进行获利。
专家解释,规定对实质性派生品种可以授权,但是其应用必须征得原始品种权人即该地方品种权利拥有者的许可。那么,地方品种权利拥有者就可以共享收益,而不是被白白取代。

因此,实质性派生品种制度,将对从源头上解决我国种业品种遗传基础窄、种子同质化严重问题,激励原始育种创新,保障粮食安全,有着重要意义。

中国农业科学院作物科学研究所 副研究员 谢永盾:只有能够得到切实的保护,就是说我们创新的产品和创新的品种能够得到切实的保护,那么我们创新的意愿和创新的投入可能更强,这样才能有效地促进我们的科技创新和优良品种的选育。
权利界定清晰 加大侵权打击力度
除了权利界定清晰,加大保护力度是此次《种子法》修改的另外一个重头戏。新法为权利人提供了更多行使权利的机会,同时,让侵权者付出更加沉重的代价。
老谷说,从他记事起,家里吃的很多蔬菜都是母亲自己种植的,那时候的种子几乎都是从街坊邻居那里凑的。

北京市民 谷先生:过去咱们说种瓜、种果、种各种蔬菜,实际过去的种子是比如说我看你们家倭瓜长得好、形好,吃着口感好,甜。好,我到你们家去说你给我留一点种子。
老谷所说的留种子,指的是邻居将蔬果种植成熟后所形成的新种子。这在专业术语中,可以简单地称为收获材料,而初始的种子,可以简单地称为繁殖材料。

新《种子法》将植物新品种权的保护范围,由授权品种的繁殖材料延伸到了收获材料,将保护环节由生产、繁殖、销售,扩展到生产、繁殖和为繁殖而进行处理、许诺销售、销售、进口、出口以及为实施上述行为的储存。

中国社会科学院法学研究所副研究员 李菊丹:这些(保护范围和保护)环节明确了之后,如果鉴定出来(使用者)所存储的繁殖材料跟它是授权品种的话,那(品种权人)是可以控告(使用者)侵权。
专家介绍,在具体实施中,如果遇到品种权人主张权利,种子使用者可以通过合法来源抗辩,比如提供从上家购买时的合同,最终将侵权责任追溯到生产侵权种子的主体。这样就可以形成品种权人与种子使用者之间的联动机制,有利于提高法律实施效率。

中国社会科学院法学研究所副研究员 李菊丹:它(新种子法)是建立这样一个机制,把它反馈回去,让(侵权人)来承担责任。但是这样的一个实施过程其实不是这个法律实施的最终目的,最终目的实际上是让种业整个生产链条当中所有商业经营主体都要知道你所经营的这样一个品种是有品种权保护的。

为了提高对侵害植物新品种权行为的威慑力,新《种子法》加大了侵权赔偿力度,将惩罚性赔偿数额倍数的上限由三倍提高到五倍,将法定赔偿数额的上限由三百万元提高到五百万元。
我国是农业用种大国,农民是用种主体,综合考虑各方情况,修改后的《种子法》保留了农民自繁自用授权品种繁殖材料的权利。

其中,新《种子法》第二十九条规定,农民自繁自用授权品种的繁殖材料,可以不经植物新品种权所有人许可,不向其支付使用费,但不得侵犯植物新品种权所有人依照本法、有关法律、行政法规享有的其他权利。

中国社会科学院法学研究所副研究员 李菊丹:比如你是农民,除了你们家自己种的,还有包了三户,你们家自己种的(家庭联产承包)证书上规定的亩数范围内,那是属于自繁自用。你承包了别人家的,虽然他们家也是家庭联产承包,但是他已经承包给你了,他转承包的时候就变成一个商业行为了。所以你家本来是三亩,然后你包了张三、李四、王五家一共十二亩,那么九亩就是属于商业运营,你是不能自繁自用的。

《种子法》第三十七条还规定,农民个人自繁自用的常规种子有剩余的,可以在当地集贸市场出售串换,不需要办理种子生产经营许可证。但专家提示,这里只是规定了不需要办理种子生产经营许可证,不能销售超出自繁自用数量的种子。大量销售超出自繁自用数量的种子,是一种侵害品种权的违法行为,需要承担相应的法律责任。
种业科技自立自强 种源自主可控
其实,植物新品种权保护的不仅仅是粮食、蔬菜和果树等可食用的植物,观赏类植物也在其中。
这是国家一级重点保护植物中的珍品珙桐,有植物活化石之称。它主要分布在瓦屋山的中高山区,与各种阔叶林组成一道绿色长廊。临海花簇相拥,白花绿叶相间,非常漂亮,随风飘动的珙桐花还有一个别致的称号,叫鸽子花。

瓦屋山国家森林公园林业工程师 黄永浩:因为它的花瓣苞片在变白了的时候,风一吹就像鸽子在飞一样的,它一多起来就像一群一群的鸽子。所以说根据它外形的特征,就把它俗语就叫中国鸽子花。

这是北京市一级保护植物槭叶铁线莲,它的花朵直径有5~6厘米,花萼基本为白色,有5~8片不等,少量还略带粉色,主要生长在石灰岩的崖壁上。
北京林业大学生态与自然保护学院副教授 谢磊:4月份开花,5月初种子成熟。它的发芽率成功率是非常非常高的,但是它这个种子只能飞到崖壁的石缝里边,它才能成功的长出来,如果落到了平地上基本上就活不了了

为进一步鼓励育种创新,此次新《种子法》在第九条增加了新内容,“重点收集珍稀、濒危、特有资源和特色地方品种”。

中国社会科学院法学研究所副研究员 李菊丹:特色、珍稀的这种(植物遗传)资源,它可以提取出功能性的一些基因,进行一个更为广泛的开发利用,有它的价值。

种质资源是带有遗传密码的物质载体,对培育新品种有着重要价值。根据2021年初数据,我国粮食种子自主选育的品种种植面积占到95%以上,做到了“中国粮主要用中国种”。猪牛羊等畜禽和部分特色水产种源立足国内有保障,现在畜禽、水产的核心种源自给率分别达到75%和85%。

但同时,农业领域的自主创新能力还不强,特别是在育种的理论和关键核心技术方面,我国和国际先进水平相比还有较大差距,种业创新的主体企业竞争力不强,存在小、散、低、重等问题。
种业科技自立自强、种源自主可控,继1962年出台《关于加强种子工作的决定》后,时隔60年,中央再次对种业发展作出重要部署。2021年7月9日,全面深化改革委员会,审议通过《种业振兴行动方案》,提出了种业振兴的指导思想、基本原则、重点任务和保障措施等一揽子安排,为打好种业翻身仗、推动我国由种业大国向种业强国迈进提供了路线图、任务书。
民以食为天,粮以种为先。一粒种子可以改变一个世界,一个品种可以造福一个民族。法治,正为培育具有自主知识产权的优良品种,一路护航。
春节假期,匆匆而过,相信不少人还在回味这些天吃到的美食。同样的蔬果,可能却是不同的品种,也有着不同的口感。2022年3月1日即将实施的新《种子法》,聚焦植物新品种知识产权保护,提高法治化水平,在育种者、生产经营者、使用者之间建立平衡的权利义务关系,为原始创新提供法治保障。
北京市民 谷先生:咱们以前吃的西红柿是你只要是咬一口,有那种西红柿的香味,说我这个是西红柿味。现在你咬一口西红柿可能就没那种味道,就是有西红柿的形状颜色,但是你说那味道差得就太远了。
老谷是土生土长的北京昌平人,这个春节,老谷家年夜饭共准备了22道菜。他所感觉到的西红柿的变化,其实隐藏着与种子有关的秘密。

以西红柿为例,西红柿原产南美洲的秘鲁、厄瓜多尔等地,后传至墨西哥,驯化为栽培种,约在明代万历年间传至中国。记忆中小时候吃的西红柿,大多皮薄汁多味浓,但易腐烂,不耐运输。随着西红柿种植的商业化,为了方便远途运输、长期储存,减少运输销售损耗,适应丰富的市场需求,又引进和培育了各种不同的西红柿品种,有鲜食品种、罐装品种和加工品种,有不同颜色的品种,有不同果形的品种,有不同生长期的品种,还有不同酸甜度的品种,满足人们日益多元化的消费需求。
还有很多我们熟悉的食材,种源并不在中国。

这是我们经常食用的白色金针菇,它的菌种几乎都来自日本一家公司。虽然我国早在上个世纪80年代末就在栽培金针菇,但是我们的金针菇品种都是黄色,所以,对这种白色的金针菇,我国每年要花费三四千万元进口它的菌种。
谢永盾是中国农业科学院作物科学研究所的副研究员,从事小麦育种十几年。

中国农业科学院作物科学研究所副研究员 谢永盾:我们的梦想其实很简单,一个是让我们的国民能够吃饱,这是我们最基础的目标,在吃饱的基础上要让大家吃好,要能够吃出来我们想要的味道。
舌尖上的鲜美食材,除了部分来自野生生物资源,更多的是来自人工养殖。对人工养殖来说,不管是动物,还是植物,种源都至关重要。
种业科技自强自立、种源自主可控,是保障国家粮食安全的重要基础,而建立激励和保护原始创新的种业法律制度,是“打好种业翻身仗”的关键。

2021年12月24日,全国人大常委会通过了修改《种子法》的决定,自2022年3月1日起施行,这是《种子法》的第四次修订,全面强化了品种权的保护力度,将我国植物新品种保护水平推向新高度。

1978年改革开放后我国种业发展史历经了三次大的变革。从1979年开始到2000年《种子法》出台前,是“四化一供”阶段,就是以县为单位组织统一供种,实行种子生产专业化、加工机械化、质量标准化和品种布局区域化,这是第一次大变革。

中国社会科学院法学研究所副研究员 李菊丹:农民对种子需求的量和多样性,从90年代中末期之后就开始变得多样化了。这种(种子)单一的供给的形式,(以及)科研的这种体制,还有(资源)配给的这种方式,也难以适应当时的一个市场需求。那么国家肯定也是都能够发现到各个领域的这样的一种变化,然后开始出台(种子法)。种子法是管理种子市场的需要来出台的。

2000年12月1日,《种子法》正式出台实施。从此,我国正式迈进种子市场化阶段,打破行政区划垄断经营种子,鼓励科研单位建立种子公司,将竞争性机制引进种子行业,这是第二次大变革。
中国社会科学院法学研究所副研究员 李菊丹:(当时的《种子法》)内容主要倾向于应该是确立一些种子企业的地位,就是市场化的这种地位。种子的生产销售要开始市场化运营,而需要有一个法律对它进行规制管理。

2011年,《国务院关于加快推进现代农作物种业发展的意见》出台,我国进入现代种子产业阶段,建立起以产业为导向、基地为依托、产学研相结合、育繁推一体化的产业体系,这是第三次大变革。

中国社会科学院法学研究所副研究员 李菊丹:以企业为主体的申请品种权的数量明显增加,企业育种创新的地位逐渐开始起来。因为要发展现代种业,这个种业一定是以市场为机制建立起来的,整个的一个种业的(产业)链条。

植物新品种是一种有生命的发明,伴随我国种业的不断发展,2015年,《种子法》在2004年、2013年两次修改后,迎来第三次修改,这次修改首次设立了植物新品种保护专章。

中国社会科学院法学研究所副研究员 李菊丹:条例(1997年制定的《植物新品种保护条例》)相对来说位阶比较低,另外对某些民事的赔偿没有在法律当中得到体现。到了2015年的时候,就把种子法当中单独设立了一个植物新品种保护,第二个是改革了(主要农作物)品种审定制度,增加了品种登记制度,表明了品种权要跟(品种创新)保护,要和种子市场的管理紧密结合在一起。
保护创新 新法从哪些方面进行重要修改
保护知识产权就是保护创新,即将于3月1日实施的第四次修改的《种子法》,从哪些权利需要保护、如何保护等方面进行了重要修改。
这是国际科技期刊《自然—植物》近期刊登的一项科研成果,是我国科学家在小麦基因育种方面的又一大突破。
中国农业科学院作物科学研究所叶兴国团队,用13年科技攻关,在30多个候选小麦再生基因样本中,发现了小麦沃克斯五基因,利用这个基因辅助基因工程育种,有望改进优良小麦品种在抗病性、抗逆性和品质方面存在的缺点,延长优良品种的寿命。

中国农业科学院作物科学研究所研究员 叶兴国:比如说我们国家有个非常著名的春小麦品种叫“宁春4号”,它的产量非常高,品质也非常好,但是它有个非常大的缺点就是不抗小麦白粉病。我们通过转基因的方法或者是基因编辑的方法,将一个抗白粉病基因转到“宁春4号”里面。通过基因编辑的方法,它就获得了对白粉病的抗性。获得这个抗病性之后,它就可以在生产上继续利用十年、二十年。
专家表示,利用这个再生基因可以对几乎所有小麦品种进行转基因改良和基因编辑改良。
基因编辑技术的创新,为植物新品种保护带来了一个难题,就是通过基因编辑等新技术手段,对原有品种进行改良,形成新的植物品种,能否获得独立的植物新品种权保护呢?例如,叶兴国教授提到的小麦品种“宁春4号”,如果导入这个抗白粉病基因,形成新的植物品种,与“宁春4号”之间在法律上具有什么关系?
实践中,通过系统选育、转基因获得、连续回交或者诱变等等不同的育种方式,都有可能在别人培育而成的优质品种上产生新的植物品种。那么,原始品种和新品种的权利保护范围该如何界定呢?

中国农业科学院作物科学研究所副研究员 谢永盾:我们审定一个小麦品种大概需要8到10年的时间。也就是说从一开始我们两个亲本进行杂交开始,我们形成稳定的品系,包括中间我们利用一些其他(技术)手段作为快速繁殖,之后还有一个我们国家的区试过程,最终下来我们要形成一个品种,大概是8到10年的时间。我们最担心的还是这个品种很容易就被别人借鉴和抄袭。
一方面,有人提出,很多农作物育种周期长、投入大、风险高,原始品种育种人用十几年或一生的心血,甚至通过几代人的努力才能培育出一个突破性的新品种。而后来人在原始品种上稍加改造,就能得到一个新品种,在某些情况下,新品种性状的改变并无实际生产意义,如果在此种情况下,赋予新品种独立的植物品种权保护,这对原始品种育种人来说,明显不公平。

中国社会科学院法学研究所副研究员 李菊丹:如果(你培育)一个原始创新的成果出来,可以随便让人使用的话,这个原始创新的动力就明显不足。这个不足虽然是短期内看不出来,但长期内就会出现模仿育种,修饰性育种很多。最后造成了这一个作物的育种基础越来越狭窄,就像有点近亲繁殖的。一旦遇到了某些突发的自然灾害或什么(病虫害),那么我们的品种种子的安全、粮食的安全就会受到影响。
另一方面,有人提出,如果不给予新品种植物新品种权,就有可能会造成原始品种育种者的故步自封,从而遏制对原有品种的改良创新活动。

就此,这次新修订的《种子法》借鉴国际植物新品种保护公约1991文本,引入了“实质性派生品种”制度。新《种子法》第九十条明确规定,实质性派生品种是指由原始品种实质性派生,或者由该原始品种的实质性派生品种派生出来的品种,与原始品种有明显区别,并且除派生引起的性状差异外,在表达由原始品种基因型或者基因型组合产生的基本性状方面与原始品种相同。

中国社会科学院法学研究所副研究员 李菊丹:所以建立这个制度,只要是跟这个品种作为一个基础的形成后续的第一代派生品实质性派生品种,第二代派生品种的这些商业性的利用,它应当获得原始品种权利人的许可。这个许可的意思其实就是你要向他交费付费,使得他这样的一个育种创新能够得到延续。
实质性派生品种制度的引入,既表达了国家保护原始育种创新,遏制“剽窃育种”的决心,也为植物新品种的后续改良和推广应用,建立了合理的利益分享机制。

中国社会科学院法学研究所副研究员 李菊丹:有了这个(实质性派生品种)制度的支持,他们(原始品种权人)就可以放心了,所有人包括用换马甲方式的使用方式,或者什么样的生物技术,这样的育种方式进行改造的行为,都将是对它这个品种的使用,他(原始品种权人)都能从这个当中进行获利。
专家解释,规定对实质性派生品种可以授权,但是其应用必须征得原始品种权人即该地方品种权利拥有者的许可。那么,地方品种权利拥有者就可以共享收益,而不是被白白取代。

因此,实质性派生品种制度,将对从源头上解决我国种业品种遗传基础窄、种子同质化严重问题,激励原始育种创新,保障粮食安全,有着重要意义。

中国农业科学院作物科学研究所 副研究员 谢永盾:只有能够得到切实的保护,就是说我们创新的产品和创新的品种能够得到切实的保护,那么我们创新的意愿和创新的投入可能更强,这样才能有效地促进我们的科技创新和优良品种的选育。
权利界定清晰 加大侵权打击力度
除了权利界定清晰,加大保护力度是此次《种子法》修改的另外一个重头戏。新法为权利人提供了更多行使权利的机会,同时,让侵权者付出更加沉重的代价。
老谷说,从他记事起,家里吃的很多蔬菜都是母亲自己种植的,那时候的种子几乎都是从街坊邻居那里凑的。

北京市民 谷先生:过去咱们说种瓜、种果、种各种蔬菜,实际过去的种子是比如说我看你们家倭瓜长得好、形好,吃着口感好,甜。好,我到你们家去说你给我留一点种子。
老谷所说的留种子,指的是邻居将蔬果种植成熟后所形成的新种子。这在专业术语中,可以简单地称为收获材料,而初始的种子,可以简单地称为繁殖材料。

新《种子法》将植物新品种权的保护范围,由授权品种的繁殖材料延伸到了收获材料,将保护环节由生产、繁殖、销售,扩展到生产、繁殖和为繁殖而进行处理、许诺销售、销售、进口、出口以及为实施上述行为的储存。

中国社会科学院法学研究所副研究员 李菊丹:这些(保护范围和保护)环节明确了之后,如果鉴定出来(使用者)所存储的繁殖材料跟它是授权品种的话,那(品种权人)是可以控告(使用者)侵权。
专家介绍,在具体实施中,如果遇到品种权人主张权利,种子使用者可以通过合法来源抗辩,比如提供从上家购买时的合同,最终将侵权责任追溯到生产侵权种子的主体。这样就可以形成品种权人与种子使用者之间的联动机制,有利于提高法律实施效率。

中国社会科学院法学研究所副研究员 李菊丹:它(新种子法)是建立这样一个机制,把它反馈回去,让(侵权人)来承担责任。但是这样的一个实施过程其实不是这个法律实施的最终目的,最终目的实际上是让种业整个生产链条当中所有商业经营主体都要知道你所经营的这样一个品种是有品种权保护的。

为了提高对侵害植物新品种权行为的威慑力,新《种子法》加大了侵权赔偿力度,将惩罚性赔偿数额倍数的上限由三倍提高到五倍,将法定赔偿数额的上限由三百万元提高到五百万元。
我国是农业用种大国,农民是用种主体,综合考虑各方情况,修改后的《种子法》保留了农民自繁自用授权品种繁殖材料的权利。

其中,新《种子法》第二十九条规定,农民自繁自用授权品种的繁殖材料,可以不经植物新品种权所有人许可,不向其支付使用费,但不得侵犯植物新品种权所有人依照本法、有关法律、行政法规享有的其他权利。

中国社会科学院法学研究所副研究员 李菊丹:比如你是农民,除了你们家自己种的,还有包了三户,你们家自己种的(家庭联产承包)证书上规定的亩数范围内,那是属于自繁自用。你承包了别人家的,虽然他们家也是家庭联产承包,但是他已经承包给你了,他转承包的时候就变成一个商业行为了。所以你家本来是三亩,然后你包了张三、李四、王五家一共十二亩,那么九亩就是属于商业运营,你是不能自繁自用的。

《种子法》第三十七条还规定,农民个人自繁自用的常规种子有剩余的,可以在当地集贸市场出售串换,不需要办理种子生产经营许可证。但专家提示,这里只是规定了不需要办理种子生产经营许可证,不能销售超出自繁自用数量的种子。大量销售超出自繁自用数量的种子,是一种侵害品种权的违法行为,需要承担相应的法律责任。
种业科技自立自强 种源自主可控
其实,植物新品种权保护的不仅仅是粮食、蔬菜和果树等可食用的植物,观赏类植物也在其中。
这是国家一级重点保护植物中的珍品珙桐,有植物活化石之称。它主要分布在瓦屋山的中高山区,与各种阔叶林组成一道绿色长廊。临海花簇相拥,白花绿叶相间,非常漂亮,随风飘动的珙桐花还有一个别致的称号,叫鸽子花。

瓦屋山国家森林公园林业工程师 黄永浩:因为它的花瓣苞片在变白了的时候,风一吹就像鸽子在飞一样的,它一多起来就像一群一群的鸽子。所以说根据它外形的特征,就把它俗语就叫中国鸽子花。

这是北京市一级保护植物槭叶铁线莲,它的花朵直径有5~6厘米,花萼基本为白色,有5~8片不等,少量还略带粉色,主要生长在石灰岩的崖壁上。
北京林业大学生态与自然保护学院副教授 谢磊:4月份开花,5月初种子成熟。它的发芽率成功率是非常非常高的,但是它这个种子只能飞到崖壁的石缝里边,它才能成功的长出来,如果落到了平地上基本上就活不了了

为进一步鼓励育种创新,此次新《种子法》在第九条增加了新内容,“重点收集珍稀、濒危、特有资源和特色地方品种”。

中国社会科学院法学研究所副研究员 李菊丹:特色、珍稀的这种(植物遗传)资源,它可以提取出功能性的一些基因,进行一个更为广泛的开发利用,有它的价值。

种质资源是带有遗传密码的物质载体,对培育新品种有着重要价值。根据2021年初数据,我国粮食种子自主选育的品种种植面积占到95%以上,做到了“中国粮主要用中国种”。猪牛羊等畜禽和部分特色水产种源立足国内有保障,现在畜禽、水产的核心种源自给率分别达到75%和85%。

但同时,农业领域的自主创新能力还不强,特别是在育种的理论和关键核心技术方面,我国和国际先进水平相比还有较大差距,种业创新的主体企业竞争力不强,存在小、散、低、重等问题。
种业科技自立自强、种源自主可控,继1962年出台《关于加强种子工作的决定》后,时隔60年,中央再次对种业发展作出重要部署。2021年7月9日,全面深化改革委员会,审议通过《种业振兴行动方案》,提出了种业振兴的指导思想、基本原则、重点任务和保障措施等一揽子安排,为打好种业翻身仗、推动我国由种业大国向种业强国迈进提供了路线图、任务书。
民以食为天,粮以种为先。一粒种子可以改变一个世界,一个品种可以造福一个民族。法治,正为培育具有自主知识产权的优良品种,一路护航。


